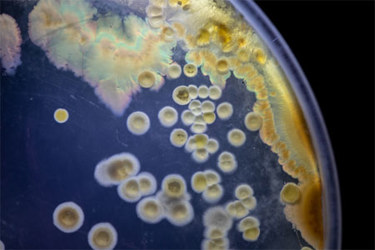

Fluorescent Bacterial Colony Selection Using QPix 400 Systems
This content is brought to you by Molecular Devices, a Danaher Operating Company.
Screening bacterial transformants that harbor a plasmid ligated with the gene of interest has become significantly more convenient with the use of vectors containing fluorescent reporter genes. Fluorescence imaging and screening provide unique insights into individual colonies, which is particularly useful when studying protein folding or secretion, enzyme evolution, or protein localization.
Traditional manual picking of microbial colonies is both time-consuming and tedious. The QPix 400 Series, equipped with a fluorescence imaging module, significantly reduces downstream processing time by enabling the phenotypic selection of unique colonies based on their levels of fluorescent protein expression. This series is a leading microbial colony picker in the market that offers multiple fluorescent filters compatible with a wide range of fluorescent cloning vectors. The fluorescence-based recombinant colony screening method facilitates the selection of gene fusion products by detecting intrinsic levels of fluorescence expression to provide higher screening fidelity for selecting recombinant colonies.
Access the full application note to learn more.
Get unlimited access to:
Enter your credentials below to log in. Not yet a member of Pharmaceutical Online? Subscribe today.